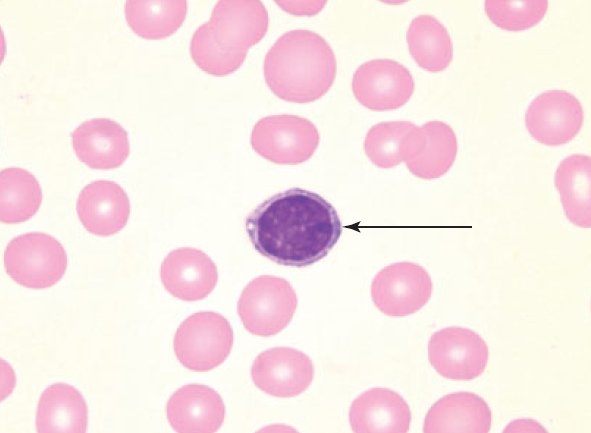

Лимфоциты ручной метод
Предложения с как будто примеры
400 022
Осенние ладошки рисунки
Интегральные показатели социально экономического развития
P0597 шевроле
Машина e power
Краткая характеристика героев драмы гроза
Peroxide starrk
Наш дом москва адреса
Сколько весят всмпо
Почему т 9 назвали т 9
Численность спб 2024 год
В 1с сбилась нумерация документов
Лимфоциты ручной метод 115 фото